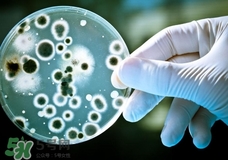
諾如病毒會死嗎?諾如病毒可以致人死亡嗎?

歡迎您,來到5號網(wǎng)!
時間:2017-03-08 14:48:13 編輯:5號網(wǎng)-pmm 1491
初春是諾如病毒的高發(fā)季節(jié),醫(yī)院里面很多兒童都是這個病,有些媽媽過于擔心寶寶了。那么諾如病毒會死嗎?諾如病毒可以致人死亡嗎?
諾如病毒一般不會致人死亡。諾如病毒會引起胃腸道感染。主要癥狀為惡心、嘔吐、腹部痙攣性腹瀉,通常持續(xù)1-2天,一般在感染病毒后12-48小時出現(xiàn)癥狀。潛伏期多在24~48h,最短12h,最長72h。感染者發(fā)病突然,主要癥狀為惡心、嘔吐、發(fā)熱、腹痛和腹瀉。兒童患者嘔吐普遍,成人患者腹瀉為多,24h內(nèi)腹瀉4~8次,糞便為稀水便或水樣便,無黏液膿血。大便常規(guī)鏡檢WBC<15,未見RBC。原發(fā)感染患者的嘔吐癥狀明顯多于續(xù)發(fā)感染者,有些感染者僅表現(xiàn)出嘔吐癥狀。此外,也可見頭痛、寒顫和肌肉痛等癥狀,嚴重者可出現(xiàn)脫水癥狀。
做好隔離杜絕傳播:如果家庭里已經(jīng)有家庭成員感染諾如病毒,則需要進行自我隔離,待病情痊愈后三天才可以上班或者上學。
做好防護徹底消毒:被患者嘔吐物和糞便污染的被服、地板等物體表面用含有效氯1000mg/L的含氯消毒液清洗和噴灑(拖地、擦洗)。被污染的衣物也可采用煮沸消毒的方法。拖把、抹布等清潔用具也需用含氯消毒劑浸泡消毒。在進行消毒處理的時候,自己也要戴口罩和手套,做好個人防護。
做好個人衛(wèi)生:重要事情說三遍:勤洗手,勤洗手,勤洗手,經(jīng)常用熱水和肥皂徹底洗手,尤其是飯前,飯后,以及便后這三個時間。

1.諾如病毒一般會自我治愈,請家長保持冷靜,不必過于驚慌。
2.請各位家長對孩子進行健康教育,幫助孩子養(yǎng)成良好的個人衛(wèi)生習慣。

3.孩子出現(xiàn)疑似情況后,請不要堅持來上幼兒園,要及時就醫(yī),并告知老師。
4.切勿使用抗生素,以免延誤病情。
5.如班上出現(xiàn)大規(guī)模嘔吐現(xiàn)象,家長需冷靜面對,先去醫(yī)院治療查詢病因,不要盲目認定為“食物中毒”。
相關(guān)文章
熱門文章
5H跟帖
最熱標簽
精選文章
美容養(yǎng)生醫(yī)療母嬰
猜你喜歡
網(wǎng)站簡介|網(wǎng)絡(luò)營銷|法律聲明|友情鏈接|聯(lián)系我們|意見反饋
Copyright ? 2012 - 2015 5h.com All Rights Reserved 5號健康網(wǎng)版權(quán)所有 鄂ICP備15005143號-3
提示:本站信息僅供參考,不能作為診斷及醫(yī)療的依據(jù);請謹慎參閱,本站不承擔由此引起的法律責任。本網(wǎng)站敬告網(wǎng)民:身體若有不適,請及時到醫(yī)院就診。
所有文章來自互聯(lián)網(wǎng) 如有異議 請與本站聯(lián)系 本站為非贏利性網(wǎng)站 不接受任何贊助和廣告
網(wǎng)友評論僅供其表達個人看法,并不表明5h立場。